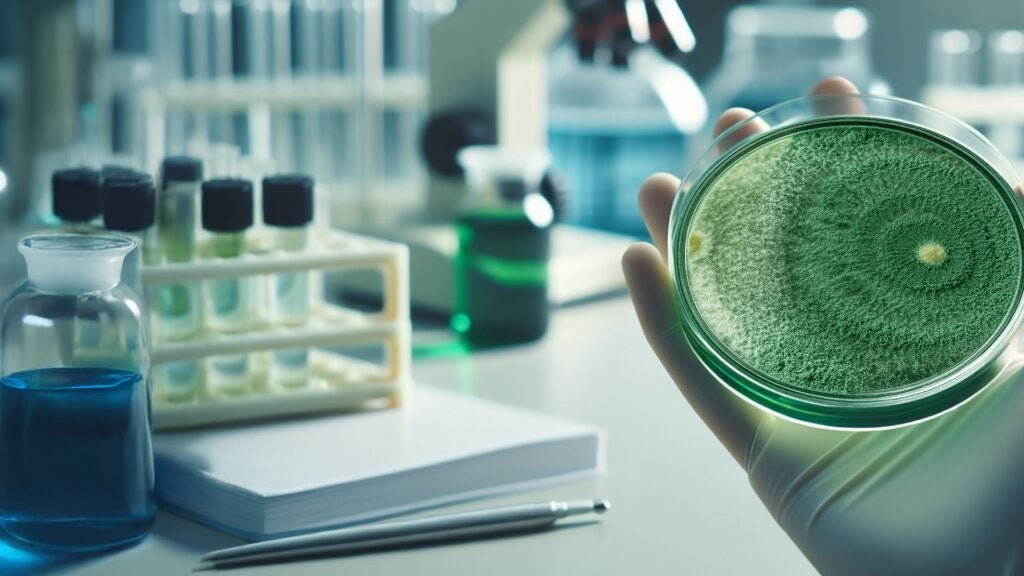

Koppert Brasil confirma presença na Dinetec 2026, que inicia nesta quarta-feira (14)

Líder global em soluções biológicas, a empresa apresenta portfólio de alta performance em uma das maiores feiras da Região Centro-Oeste do país
A Koppert Brasil está confirmada na Dinetec 2026, uma das principais vitrines do agronegócio da Região Centro-Oeste, que acontece de 14 a 16 de janeiro, em Canarana (MT). Nesta edição, a empresa apresenta soluções inovadoras de alto desempenho em controle biológico, manejo integrado de pragas e doenças, voltadas para culturas estratégicas como soja, milho, cana, algodão e arroz.
Líder global em bioinsumos para agricultura, a Koppert é convidada no estande do Grupo Sinova, plataforma de distribuição referência na cadeia do agronegócio brasileiro. Além disso, uma equipe técnica especializada estará disponível para conversar com produtores rurais, fornecedores e parceiros.
Entre os destaques apresentados estão os lançamentos Buick Evo® (SfMNPV) e Trichodermil FS® (Trichoderma asperelloides ESALQ 1306), o único biodefensivo no mundo desenvolvido à base de fungo – cepa exclusiva – para o tratamento de sementes industrial (TSI).
Trichodermil FS® protege a planta desde o “berço”, favorece o desenvolvimento radicular, promove um arranque vigoroso, estimula os mecanismos naturais de defesa da planta, inibe a ação de fungos e nematoides de raiz. Além disso, prolonga o tempo de armazenamento das sementes mesmo após o tratamento.
Já o Buick Evo® é um bioinseticida microbiológico que age especificamente sobre a lagarta Spodoptera frugiperda, preservando inimigos naturais e o ecossistema. Um produto com ação rápida e prolongada, e compatível com diferentes métodos de controle, ideal para o manejo integrado de pragas (MIP).
Outro produto que merece destaque é o Octane® (Isaria fumosorosea ESALQ 1296), solução altamente eficaz no controle da cigarrinha-do-milho (Dalbulus maidis), cigarrinha-da-raiz (Mahanarva fimbriolata), lagarta-do-algodão (Helicoverpa armigera), ácaro-rajado (Tetranychus urticae), entre outras ameaças do campo.
Os bioinsumos apresentados fazem parte do Sistema Integrado Koppert (SIK), que oferece soluções inovadoras, incluindo monitoramento, inoculantes, bioativadores, micro e macrobiológicos, além de ferramentas tecnológicas como drones e aplicativos para compatibilidade de produtos.
“No Centro-Oeste, o produtor busca previsibilidade. Nosso papel é converter biológicos em produtividade mensurável, com posicionamento técnico, qualidade de aplicação e tomada de decisão orientada por dados. Vamos demonstrar como nosso portfólio eleva a resiliência de grandes sistemas produtivos como os da região Centro-Oeste e entrega resultados reais em campo”, afirma Marcelino Brito, Gerente de Desenvolvimento de Mercado da Koppert Brasil.
Sobre a KOPPERT BRASIL
A Koppert, líder mundial em controle biológico desde 1967, trabalha para agricultores em todo o mundo promovendo sustentabilidade e rentabilidade de cultivos, preservando a biodiversidade e contribuindo para sistemas alimentares mais seguros.
No Brasil desde 2011, conta com três modernas unidades de produção: microbiológicos em Piracicaba (SP) e unidades de formulações e de macrobiológicos em Charqueada (SP). Com processos produtivos padronizados e altamente tecnificados, a empresa assegura qualidade, rastreabilidade e escalabilidade do portfólio, além da aplicação de macrobiológicos via drones por meio da Natutec® by Koppert.
A Koppert mantém um departamento próprio de P&D voltado à agricultura tropical e é parceira do SPARCBio (São Paulo Advanced Research Center for Biological Control) e do Gazebo, primeiro hub de inovação do agronegócio especializado em controle biológico no país. Saiba mais em: www.koppert.com.br
SERVIÇO
Dinetec 2026
Data: 14 a 16 de janeiro de 2026
Local: Canarana (MT)
Programação, credenciamento e localização: www.dinetec.com.br
Por COMUNICAÇÃO KOPPERT BRASIL